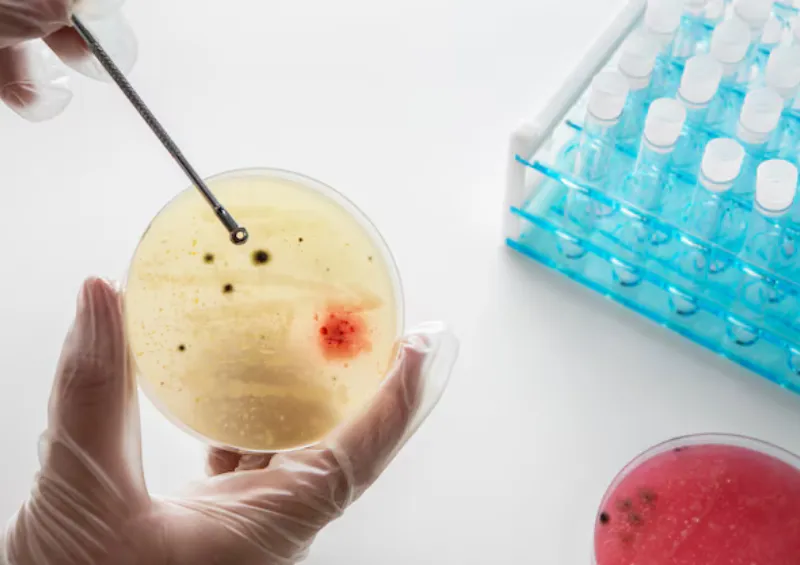
semen analysis

Treatment: Your Path to Peak Performance & Advanced Healing
Your journey to Performance 10 Years Younger begins here. We deliver regenerative care to transform your function and confidence.
Gentle Treatments, Powerful Results
Achieve complete confidence knowing all men's health and fertility issues can be solved under one roof at SuamiSiHat Clinic. Our specialized care is engineered by 7 dedicated physicians who deploy a comprehensive suite of 8 advanced treatments. This commitment to clinical mastery has earned recognition in national outlets like Astro Awani, Berita Harian, Kosmo and Digital News Asia and the community's trust, evidenced by our exceptional 4.9-star rating across over 110 patient reviews.
Why Men Choose Our Specialized Care?
Approved Medications
We prescribe and dispense only approved medications and topical treatments (Oral Solutions & External Use) that meet stringent national medical standards
Professional Physician
Treatment delivered by licensed medical doctors specialized in mens health, ensuring expert assessment and accurate diagnosis.
Easy Consultation
Easy, stress-free booking via phone/website. We prioritize private, one-on-one sessions with a doctor to discuss sensitive health concerns without undue waiting.
Trusted Among Community
4.9⭐ (110+) rating on Google Review. We prioritize confidentiality & a non-judgmental environment for all patients.
Private & Privacy Protection
Privacy is fundamental. We guarantee absolute discretion. All consultations and records are handled with strict professional ethics in a non-judgmental environment.
One Stop Centre
All men's health and fertility issues can be solved under one roof at SuamiSiHat Clinic.
List of Treatment

ESWT
No pain, big gain. This therapy is totally non-surgical and painless. It uses gentle waves to help your blood vessels grow stronger, sustained erection without any discomfort or rest time needed.
✔ Improves erection strength
✔ Non-surgical
Price from: RM699

P Shot Injection
This is advanced healing for deep problems. We use special injections to help your body repair damaged nerves and tissue.
✔ Enhances sensitivity & performance
✔ Natural growth-factor treatment
Price from: RM1,000

Stem Cell
Stem Cell Therapy is our highest level of regenerative healing, usually for severe cases. It's a precise treatment focused on deep cellular repair to give you the strongest possible chance for function recovery. It's safe and done with great care.

Kegel Chair
Getting better control is easy! Our Kegel Chair strengthens your pelvic muscles while you just relax and sit down, fully dressed. It helps you get better timing and firmness, effortlessly.
✔ Strengthens pelvic floor muscles
✔Supports stamina, control & better intimate performance
Price from: RM399

Physiotherapy
We help you heal completely. Physiotherapy gives you gentle exercises and support to make sure your muscles and body function well long-term. It's about full recovery, not just quick fixes.
✔ Improves pelvic control & reduces tightness
✔ Supports erection quality & long-term sexual function
Price from: Provided during consultation

IV Drip Protocol
Need energy now? Our IV Drip gives vitamins and nutrients straight into your body. It’s a comfortable, relaxing session that instantly fights tiredness and boosts your body's recovery.
✔ Boosts energy, focus, immunity & recovery
✔ Custom formulation for male vitality
Price from: RM799
Semen Analysis
Starting family planning is simple. Semen Analysis is a quick way to check your sperm health. This test gives us the clear information we need to plan your best optimization program easily.
✔ Evaluates sperm count, motility & morphology
✔ Provides clarity for fertility treatment planning
Price: Provided during consultation

Hormone Replacement
Tired all the time? Hormone Therapy is a simple way to feel young again. After a quick check-up, we use personalized treatment to fix your hormones, giving you better mood, energy and confidence.
✔ Restores testosterone, libido, energy & mood
✔ Doctor-guided & 100% private
Price from: RM250
INTRODUCING
Our Medical Team
Our medical team brings together experienced men’s health doctors, physiotherapists, and performance specialists. You’ll receive structured, science-driven care tailored to improve your health, confidence, and marital wellness.
Dr. Rakesh
Head of Clinic & Wellness
Dr. AMIR
Men’s Health Doctor
Dr. Jailani
Men's Health Doctor
Dr. Zakwan
Men's Health Doctor
Our Solution
Get The Best Treatment Plan Customised For You
We provide individually tailored treatment plans for each clients at an affordable cost.
We believe that everyone deserves private, personalised care and attention, and our team is fully dedicated to provide the best possible treatment.

Oral Solutions
Formulations & supplements that support circulation and improve overall men’s health & performance.

Counselling & Consultation
Professional guidance by licensed doctors that is reliable, affordable, and focused on men’s wellness.

External Use
Topical spray or cream that helps strengthen vitality and boost men’s performance naturally.

Professional Treatment & Therapy
Advanced non-invasive therapies designed to enhance men’s performance & overall health.
Featured In
As seen on major publications and media, Suami Sihat Clinic is the recognized leader for specialized men’s health and wellness.
SEE LATEST REVIEWS
What Our Clients are Saying
Secure Your Path to Performance 10 Years Younger
Don't delay your transformation. Take action today and Make Your Loved One Proud.

SS Clinic is the first and one of its kind to advocate on high quality treatment, medication as well as supplements for men's health at an affordable cost.
Operating Hours
Monday - Sunday : 10am - 5pm
Except Public Holiday
Follow Us
Corporate
About
Article
FAQ
Appointment
Review
Privacy and Policy
Terms & Condition
Service
Wellness
Men Fertility
Hormone Imbalance
Erectile Dysfunction
Premature Ejaculation
Sexually Transmitted Disease (STD)
Treatment
ESWT
P Shot Injection
Stem Cell
Kegel Chair
Physiotherapy
IV Drip Protocol
Semen Analysis
Hormone Replacement








